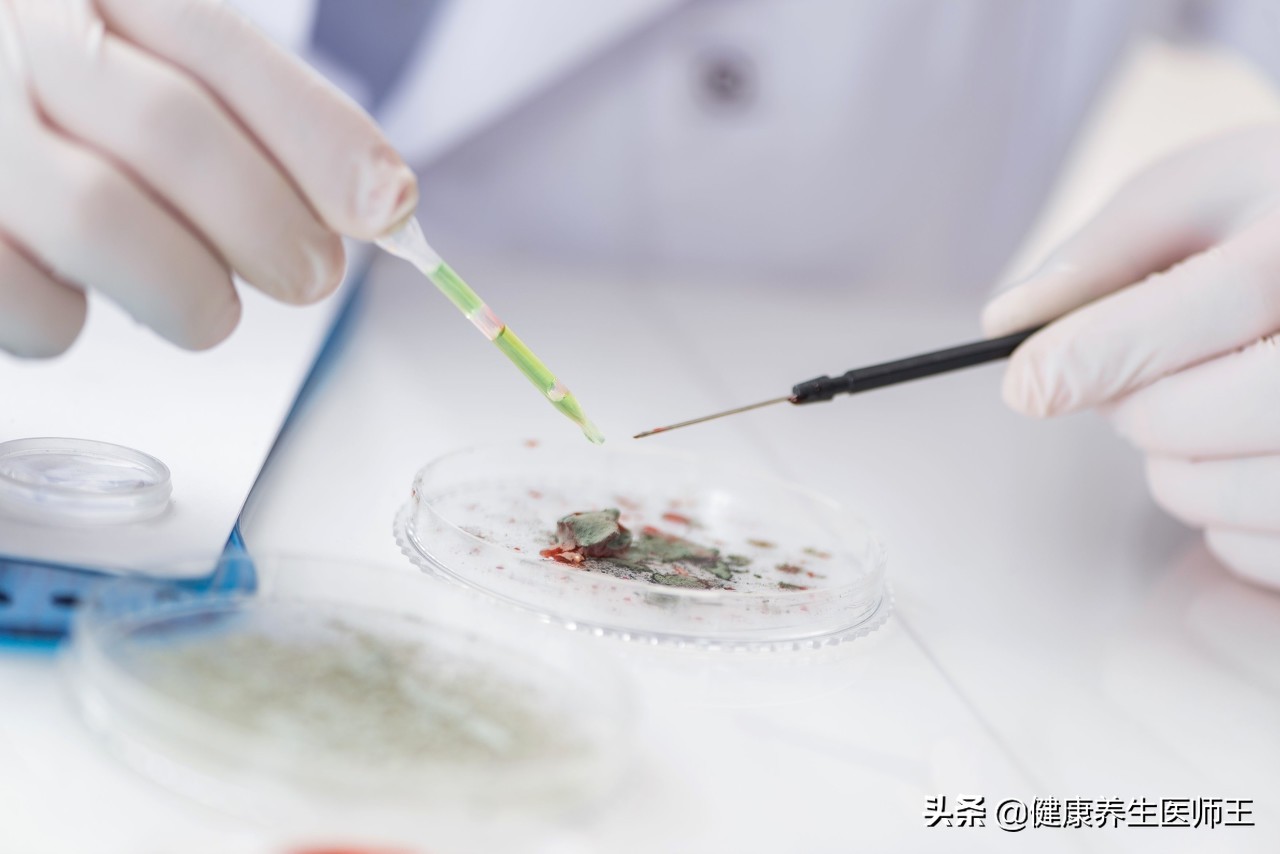
外阴良性肿瘤的症状,外阴良性肿瘤暂时不做手术可以吗

外阴良性肿瘤
外阴肿瘤包括良性肿瘤与恶性肿瘤。前者少见,后者多见于60岁以上妇女。

外阴良性肿瘤:
· 较少见,包括上皮来源和中胚叶来源两类。
确诊靠组织学诊断,治疗多采用局部肿瘤切除。
1、外阴良性肿瘤比较少见,主要有上皮来源的外阴乳头瘤、汗腺腺瘤及中胚叶来源的纤维瘤、平滑肌瘤等。

2、外阴乳头瘤
常见于围绝经期和绝经后妇女,是以上皮增生为主的病变。是以上皮增生为主的病变。主诉多为发现外阴肿物和搔痒,检查可见阴唇肿物,见多个乳头状突起并覆有油脂性物质,表面常因反复摩擦可破溃、出血、感染。诊断借助于活组织病理检查明确性质。镜下可见复层鳞状上皮,上皮的钉脚变粗并向真皮纤维结缔组织内伸展。应注意与疣状乳头状瘤、外阴湿疣、软纤维瘤及外阴癌鉴别。因2%-3%有恶变倾向,应手术切除。术时作冰冻切片,若有恶变应及时扩大手术范围。
3、汗腺瘤
汗腺瘤 常见于青春期后,比较少见。来源于顶浆分泌性汗腺,由汗腺上皮增生而成,多位于大阴唇上部,边界清楚,隆起于皮肤表面,生长缓慢,直径常在1-2cm内。肿瘤包膜完整,与表皮不粘连。镜下见高柱状或立方形的腺上皮交织形成绒毛状突起。病理特征为分泌形柱状细胞下衬有一层肌上皮细胞。一般为良性,极少恶变。患者多无症状有时由于囊内的乳头状生长可溃破于壁外,可有少量出血,伴感染时有瘙痒、疼痛。治疗为先行活组织检查,确诊后行病变局部切除。
4、纤维瘤
纤维瘤 是最常见的外阴良性肿瘤。来源于外阴结缔组织,由成纤维细胞增生面成。大多发生于大阴唇,其他部位较少,常为单发,生长缓慢。一般无症状,偶尔因摩擦,表面可有溃疡,可出现下坠及疼痛症状。检查可见大阴唇绿豆到樱桃大小、光滑质硬、带蒂的赘生物。肿瘤切面为致密、灰白色纤维结构。镜下见平行的纤维索呈波浪状或互相盘绕,由成熟的成纤维细胞和胶原纤维组成。包膜为纤维结缔组织。肿瘤恶变少见。疗原则为沿肿瘤根部切除

5、平滑肌瘤
平滑肌瘤 来源于外阴平滑肌、毛囊立毛肌或血管平滑肌。多见于生育年龄妇女,常位于大阴唇、阴蒂及小阴唇。质硬,表面光滑,突出于皮肤表面。镜下见平滑肌细胞排列成束状,与胶原纤维束纵横交错或形成漩涡状结构,常伴退行性变。治疗原则为肌瘤除术。